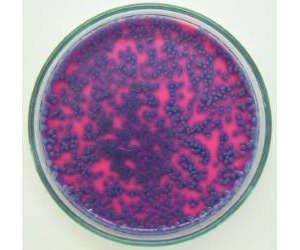
Chromoselect Bacillus Agar
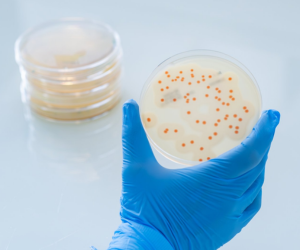
Colonies of b cereus on BACARA chromogenic media

Microbiology Buyer Directory : Food & Beverage
Sector: Food & Beverage
Test type: Chromogenic Media
Please use both selection boxes below to find companies that supply products in areas that you are interested: